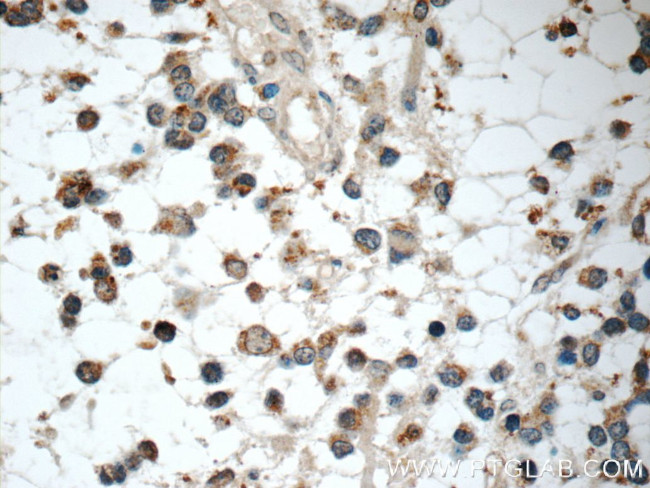
IL-1F6 / IL-36 alpha Antibody in Immunohistochemistry (Paraffin) (IHC (P))

Search
Proteintech
IL-1F6 / IL-36 alpha Polyclonal Antibody
{{$productOrderCtrl.translations['antibody.pdp.commerceCard.promotion.promotions']}}
{{$productOrderCtrl.translations['antibody.pdp.commerceCard.promotion.viewpromo']}}
{{$productOrderCtrl.translations['antibody.pdp.commerceCard.promotion.promocode']}}: {{promo.promoCode}} {{promo.promoTitle}} {{promo.promoDescription}}. {{$productOrderCtrl.translations['antibody.pdp.commerceCard.promotion.learnmore']}}
产品信息
24173-1-AP
种属反应
宿主/亚型
分类
类型
抗原
偶联物
形式
浓度
纯化类型
保存液
内含物
保存条件
运输条件
产品详细信息
Immunogen sequence: MEKALKIDT PQQGSIQDIN HRVWVLQDQT LIAVPRKDRM SPVTIALISC RHVETLEKDR GNPIYLGLNG LNLCLMCAKV GDQPTLQLKE KDIMDLYNQP EPVKSFLFYH SQSGRNSTFE SVAFPGWFIA VSSEGGCPLI LTQELGKANT TDFGLTMLF (1-158 aa encoded by BC107043 )
靶标信息
The IL-1 family is comprised of 11 structurally related ligands, including recently re-named IL-36alpha (IL-1F6), beta (IL-1F8), and gamma (IL-1F9). IL-36alpha is highly expressed in psoriatic plaques, as are IL-36beta and IL-36gamma, and is the only IL-1 family member found to be expressed by T cells, as well as monocytes and B cells. Primarily found in skin and lymphoid tissues, IL-36alpha is also found to a lesser extent in tissues of the fetal brain, trachea, stomach, and intestine. IL-36alpha signals through a combination of the IL-1Rrp2 (IL-1R6) receptor, which is primarily expressed on certain dendritic cells, and the widely expressed IL-RAcP (IL-1 receptor accessory protein). IL-36alpha also functions as an agonist of NF-kappaB and MAPK pathways, and induces the production of proinflammatory cytokines and chemokines, including IL-6, IL-8, BD-2, and BD-3.
仅用于科研。不用于诊断过程。未经明确授权不得转售。
生物信息学
蛋白别名: FIL1 epsilon; IL-1 epsilon; IL-1F6; IL-1F6 (FIL-1-epsilon); Interleukin; interleukin 1; interleukin 1 family, member 6 (epsilon); interleukin 1, epsilon; Interleukin-1 epsilon; Interleukin-1 family member 6; Interleukin-36; Interleukin-36 alpha
基因别名: FIL1; FIL1(EPSILON); FIL1E; IL-1F6; IL1(EPSILON); IL1E; IL1F6; IL36A
UniProt ID: (Human) Q9UHA7
Entrez Gene ID: (Human) 27179